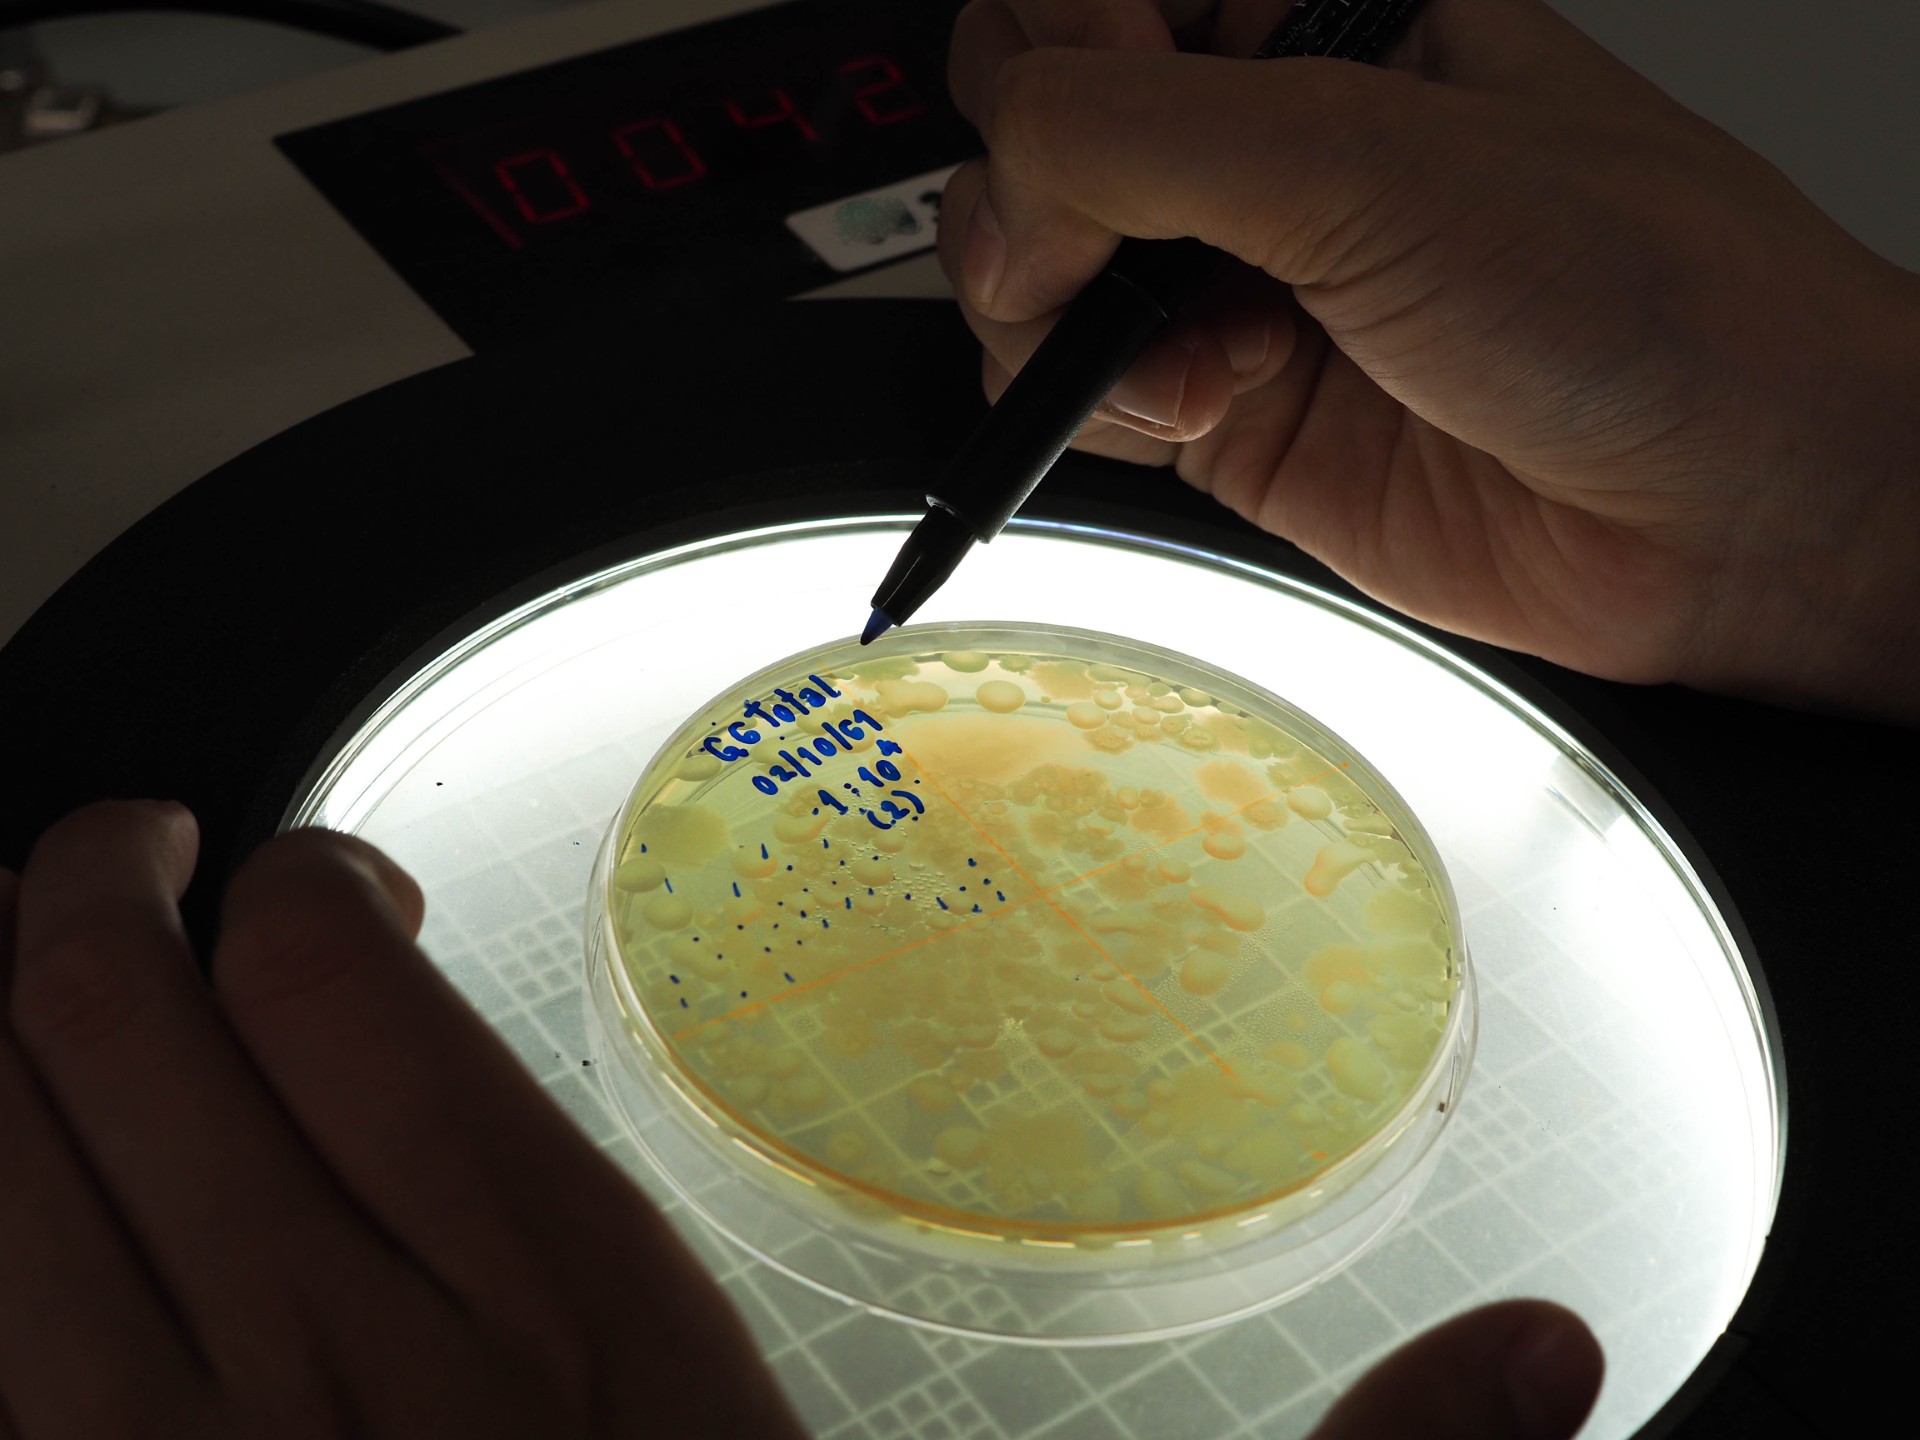

Hidden in plain sight – Nitrifying bacteria in monochlorinated distribution systems
If you are using heterotrophic plate counts (HPCs) to identify nitrifying bacteria – you won’t find them.
If you are using heterotrophic plate counts (HPCs) to identify nitrifying bacteria – you won’t find them.
As it mentions in the name, HPCs only measure heterotrophic bacteria.
These organisms feed off organic carbon compounds like fats, carbohydrates, and proteins while autotrophic bacteria produce their own food from basic energy sources like sunlight or chemical energy. Because of these differences in metabolic pathways, autotrophic organisms – like nitrifying bacteria – are not detected with standard plate counts.
Why does it matter?
Nitrifying bacteria are broken into two co-dependent groups: bacteria that will convert ammonia to nitrates (ammonia-oxidizing bacteria and ammonia-oxidizing archaea) and organisms that will convert nitrites to nitrates (Nitrobacter and Nitrospira).
These make up the nitrogen cycle which in other applications is a good and necessary part of our lives (Abhinav, 2012). In a monochloraminated drinking water distribution system however, these microorganisms can contribute to biofilm formation, loss of disinfectant residual, protection of other organisms, and microbially influenced corrosion (MIC), therefore, it’s important to monitor for and protect against them.
If they can’t be detected with HPCs, how do distribution operators accomplish this?
The management of chloraminated water systems typically involves maintaining a delicate balance between chlorine, ammonia, and pH. Several factors such as changing disinfectant demand, biofilm, and variations in naturally-occurring ammonia levels can all influence this ratio.
When the ratio is upset, it can result in a surplus of ammonia, facilitating the growth of nitrifying bacteria. Monitoring levels of chlorine residual, ammonia, nitrates, and nitrites can indicate that nitrification may be occurring but, without the ability to measure autotrophic bacteria, it can be difficult to determine the extent to which it’s occurring or to pinpoint the source of the issue. This is where ATP monitoring can help. Measuring ATP (adenosine triphosphate) levels allows operators to immediately quantify the size of the total microbial population. Therefore, microbiological growth can be identified before nitrifying bacteria are able to colonize the system and well before nitrite and nitrates levels reach concerning levels.
The dataset in Table 1 is the perfect example of this. While it appears that there is good control of nitrification at the treatment plant, multiple sample points in the distribution system indicate nitrification is occurring. Relying on chemical tests alone would have caused operators to miss the nitrification occurring at sample points 3 and 4 until it was too late and the growth had become widespread enough to deplete the chlorine residual. By implementing Luminultra’s 2nd Generation ATP solution, the operators were able to proactively identify, localize and treat the microbial issues found in their distribution system.

Table 1: Sample dataset on using ATP for nitrification monitoring.
While the increased use of monochloramine may have benefits in terms of stabilizing chlorine and reducing disinfection by-product formation, there is a trade-off in the form of nitrification that must be kept in mind. And while there are tools that can be used as indicators, HPCs will leave you in the dark when it comes to contamination from autotrophic bacteria. Ask us how you can implement 2nd Generation ATP monitoring as a proactive solution for the monitoring and control of nitrifying bacteria regrowth in your distribution system.
Bibliography:
Abhinav, V. (2012, July 20). Nitrifying bacterium. Retrieved from Encyclopaedia Britannica: https://www.britannica.com/science/nitrifying-bacterium
Fritz Industries. (n.d.). Autotropic Vs. Heterotrophic Bacteria. Retrieved from BioCon Labs: http://www.bioconlabs.com/autoheterobac.html
Gale, T. (2006). Heterotrophic Bacteria. Thomson Corporation.
Explore Luminultra resources
Make confident decisions with trusted expertise.
Discover webinars, whitepapers and expert articles focused on microbial control.





























